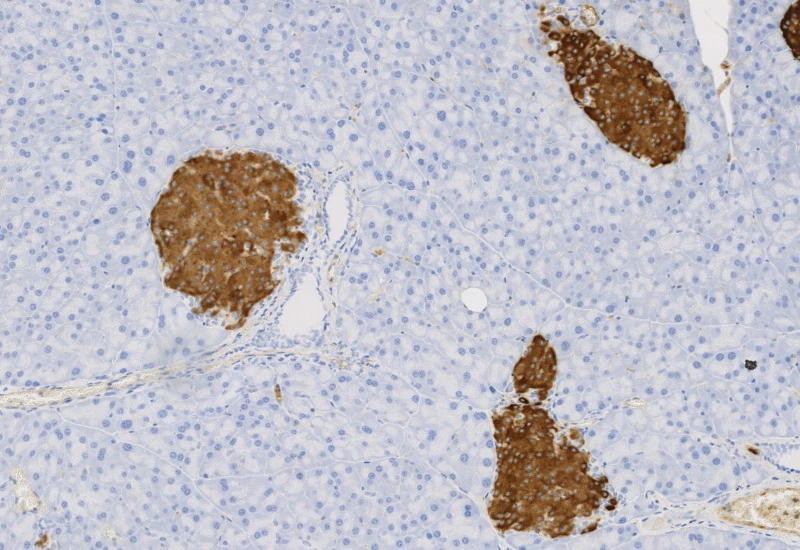

IHC Meta Cells
Detect IHC/HC-stained metastructures (e.g. islets, tumor, stroma) and segment single cells into nucleus, perinuclear area, and/or cytoplasm, classify cells inside/outside metastructures, and measure up to 20 intensity, statistic, and morphometric parameters per area and compartment.
metastructures
single-cell analysis
insulin islets, pancreas, immunohistochemistry, beta-cells, brightfield

The IHC Meta Cells App combines the detection of IHC/HC stained metastructures (e.g. Langerhans islets, Tumor - Stroma) with single cell detection (segmentation of cells into nucleus, and/or perinuclear area and/or cytoplasm). Detected cells can be classified and visualized as being either within or outside of detected metastructures. Each detected area and cell compartment is measured for up to 20 intensity, statistic and morphometric parameters.
Original image

Nuclei detection

Metastructure detection

Nuclei/metastructure detection
single-cell analysis

White Paper
30 Mar, 2026
Understanding NeuroCOVID-19: SARS-CoV-2 Disrupts Astrocyte Homeostatic Functions
metastructures

Blog Post
17 May, 2023
An Intro to Deep Learning in Biomedical Imaging
We support the following file formats:
- TissueFAXS (aqproj)
- StrataFAXS II (vmic)
- PreciPoint (vmic, gtif)
- Generic BigTIFF Import
- Support for multipage BigTIFF files
- OME-TIFF
- JPEG, PNG, BMP, TIFF
- Zeiss (czi)
- Hamamatsu NanoZoomer (ndpi)
- Aperio (svs)
- Leica (scn)
- 3D HISTECH Pannoramic
- Mirax (mrxs)
- Olympus (vsi)
- More slide scanners to be added!
Related Apps

IHC Insulin Islets
The IHC Insulin Islet App detects marker-stained insulin islets, tissue area, and cell phenotypes within and outside the islets. Outputs include tissue and islet area, cell counts, and phenotype distribution.
insulin islets, pancreas, beta-cells

IF Immune status in situ
Characterize immune cell phenotypes relative to detected metastructures (e.g. tumors, glands), define distance ranges, measure cell-to-boundary distances inside/outside, and export up to 20 intensity, statistic, and morphometric parameters per cell compartment.
colon cancer, cytotoxic t cells, tumor microenvironment, PD1, CD8, spatial analysis, fluorescence

Custom App development
Perfectly tailored image analysis solutions for your research.
You have a specific research question that needs to be answered? We offer custom development of image analysis pipelines for specific tasks, be it detection of cellular phenotypes or quantification of tissue structures. After discussing your goals with one of our experts, you will get a ready-to-use App and be a step closer to an impactful publication.
